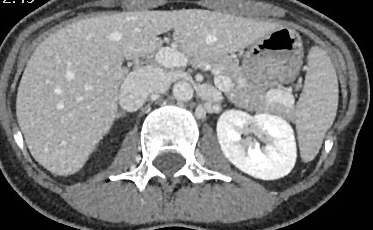
🙌🏻 Webinaire du <a href="/JURI_Fr/">Junior Radiologie Interventionnelle</a> ce soir 😎

🩻 Syndrome de congestion pelvienne avec le Pr <a href="/gsoulez/">Gilles Soulez</a> 

Patiente avec douleurs pelviennes chroniques. 
La phlébographie montre une incontinence de la veine gonadique gauche. 

Quel syndrome sous jacent suggère le scanner ?👇

<a href="/ETF_IRtrainees/">CIRSE European Trainee Forum</a>

Tradi Farouk
@farouktradi
ID: 1454685881193963522
31-10-2021 05:45:25
53 Tweet
71 Followers
89 Following

🙌🏻 Webinaire du Junior Radiologie Interventionnelle Saison 3 🩻 Radiologie interventionnelle pédiatrique avec le Dr @alexdabadie👩⚕️ AP-HM - Hôpitaux Universitaires de Marseille🏥 🗓19h00 Lundi 6 février 🧑💻Lien zoom: univ-amu-fr.zoom.us/j/87961469429?… 🎥 Replay : youtube.com/@juri6620 UNIR Radiologie CIRSE European Trainee Forum GuERI @CERFradio


🙌🏻 Webinaire du Junior Radiologie Interventionnelle ce soir 🩻 Radiologie interventionnelle pédiatrique avec le Dr @alexdabadie Le TIPS est considéré comme une intervention complexe, que dire du TIPS pédiatrique ? Quel matériel utiliser chez un enfant d'1 an ? 👇👇 SFIPP CIRSE European Trainee Forum


🙌🏻 Webinaire du JuRI Saison 3-EP 2: ☢ Prise en charge du syndrome de congestion pelvienne en RI #IRad 👨🏫 Pr Gilles Soulez /Pr frandon julien 🗓 Lundi 27 mars 19h🇫🇷/11h🇨🇦 🧑💻Lien zoom: univ-amu-fr.zoom.us/meeting/regist… SFR (Radiologie) CIRSE CIRSE European Trainee Forum Canadian Association for Interventional Radiology Society of Interventional Radiology

🙌🏻 Webinaire du Junior Radiologie Interventionnelle ce soir 😎 🩻 Syndrome de congestion pelvienne avec le Pr Gilles Soulez Patiente avec douleurs pelviennes chroniques. La phlébographie montre une incontinence de la veine gonadique gauche. Quel syndrome sous jacent suggère le scanner ?👇 CIRSE European Trainee Forum

🙌🏻 Webinar JuRI Saison 3-EP 3: ☢ Radiologie Interventionnelle au service des Femmes 👨🏫 Dr Léo Razakamanantsoa /Pr H.Vernhet/Pr JL Brun 🗓 Lundi 24 avril 19h 🧑💻Lien zoom: univ-amu-fr.zoom.us/meeting/regist… SFR (Radiologie) CIRSE CIRSE European Trainee Forum CNGOF ECIO WomeninIR


🙌🏻 Webinar JuRI Saison 3-EP 4: ☢ Radiologie Interventionnelle multi-modale : l'endovasculaire au service du percutané !! 👨🏫 Pr J.Garnon salvador cano/ Dr G.Goyault 🗓 Lundi 26 juin 19h 🧑💻Lien zoom: univ-amu-fr.zoom.us/meeting/regist… SFR (Radiologie) CIRSE CIRSE European Trainee Forum AP-HM - Hôpitaux Universitaires de Marseille

🙌Ne ratez pas les cas cliniques #JFR365 de la SFR (Radiologie) !!! 📺🍿🥤 👨🏻🎓👩🏾🎓Testez vous sur ce cas de radiologie interventionnelle hépatique 👇👇👇 jfr365.jfr.plus/cas-cliniques/… 📅 x.com/JURI_Fr/status… @CERFradio CIRSE European Trainee Forum CIRSE AP-HM - Hôpitaux Universitaires de Marseille Percut #ET2023


salvador cano SFR (Radiologie) CIRSE CIRSE European Trainee Forum AP-HM - Hôpitaux Universitaires de Marseille ☢ Radiologie Interventionnelle multi-modale : 👨🏫Comment traiter de cette endofuite aortique de type II : endovasculaire ❓ percutané ❓ #IRad La réponse au prochain Webinaire 👆👆👆 CIRSE European Trainee Forum UNIR Radiologie SFR (Radiologie) @CERFradio CIRSE Canadian Association for Interventional Radiology Percut

🙌Le Junior Radiologie Interventionnelle sera aux #JFR2023 13-16Oct SFR (Radiologie) 🩻 🧑💻Riche programme et des ⭐️Experts⭐️dédiés aux Jeunes RI Cette année format inédit Pro & Con 🥊 #UFCParis 👉👉youtu.be/B9oMfh_by_0 ✉️ [email protected] @CERFradio AP-HM - Hôpitaux Universitaires de Marseille CIRSE CIRSE European Trainee Forum

🙌Le Junior Radiologie Interventionnelle sera aux #JFR2023 13-16Oct SFR (Radiologie) ☢️ 👩🏫Quizz #1 : Comment s'appelle cette intervention ? 🧐#IRAD Réponse :👇👇👇ncbi.nlm.nih.gov/pmc/articles/P… 🎥 youtu.be/B9oMfh_by_0 🥊🫶 🤪 AP-HM - Hôpitaux Universitaires de Marseille CIRSE CIRSE European Trainee Forum UNIR Radiologie @CERFradio Canadian Association for Interventional Radiology #SFICV

🙌Le Junior Radiologie Interventionnelle sera aux #JFR2023 13-16Oct SFR (Radiologie)☢️ 👩🏫Quizz #2 : Quel médicament peut être injecté à cette position ? 🧐 Réponse :👇👇👇 pubs.rsna.org/doi/full/10.11… 🎥 youtu.be/B9oMfh_by_0 🥊🫶 🤪 AP-HM - Hôpitaux Universitaires de Marseille CIRSE CIRSE European Trainee Forum UNIR Radiologie @CERFradio #SFICV

🙌 Le Junior Radiologie Interventionnelle est aux #JFR2023 13-16Oct SFR (Radiologie)☢️ 👩🏫Quizz #2: Ponction sous echo ou rayons X ? @alexdabadie🧐#IRAD Réponse : ncbi.nlm.nih.gov/pmc/articles/P… 🎥 youtu.be/B9oMfh_by_0 🥊🫶 🤪 AP-HM - Hôpitaux Universitaires de Marseille CIRSE CIRSE European Trainee Forum UNIR Radiologie @CERFradio Canadian Association for Interventional Radiology #SFICV

🙏 Merci aux #JFR2023 SFR (Radiologie) ☢️🩻👩⚕️ 🤩De superbes sessions Junior Radiologie Interventionnelle , de l'enthousiasme, du débat, du fun, des experts. #irad 🎥 Programme complet à retrouver en Replay sur JFR.plus 🍿 🎁Merci à la #SFICV pour le soutien ✉ [email protected]


🙌🏻 Webinar JuRI Saison 4: ☢️Radiologie Interventionnelle dans les voies biliaires : Quand et comment❓ 👨🏫 Dr A. Fooz/ 👩🏫 Dr A. RODE HCL - Hospices Civils de Lyon 🗓 Lundi 15 avril 19h 🧑💻Lien zoom: univ-amu-fr.zoom.us/meeting/regist… SFR (Radiologie) @CERFradio CIRSE European Trainee Forum UNIR Radiologie AP-HM - Hôpitaux Universitaires de Marseille

🎥 Replay disponible youtu.be/DO4rFVPN9oM?si… 👍👍👍 CIRSE European Trainee Forum UNIR Radiologie SFR (Radiologie) @CERFradio CIRSE Canadian Association for Interventional Radiology AP-HM Story HCL - Hospices Civils de Lyon

🙌Le Junior Radiologie Interventionnelle sera aux #JFR2024 4-7Oct SFR (Radiologie) 🩻 🧑💻Riche programme et des ⭐️Experts⭐️dédiés aux Jeunes radiologues interventionnels Cette année encore un jeu concours au format inédit #Paris2024 ✉️ [email protected] @CERFradio CIRSE CIRSE European Trainee Forum


🙏 Merci aux #JFR2024 SFR (Radiologie) ☢️🩻👩⚕️ 🤩De superbes sessions Junior Radiologie Interventionnelle , de l'enthousiasme, du débat, du fun, des experts. #irad 🎥 Programme complet à retrouver en Replay sur JFR.plus 🍿 🎁Merci à la #SFICV pour le soutien ✉ [email protected]
